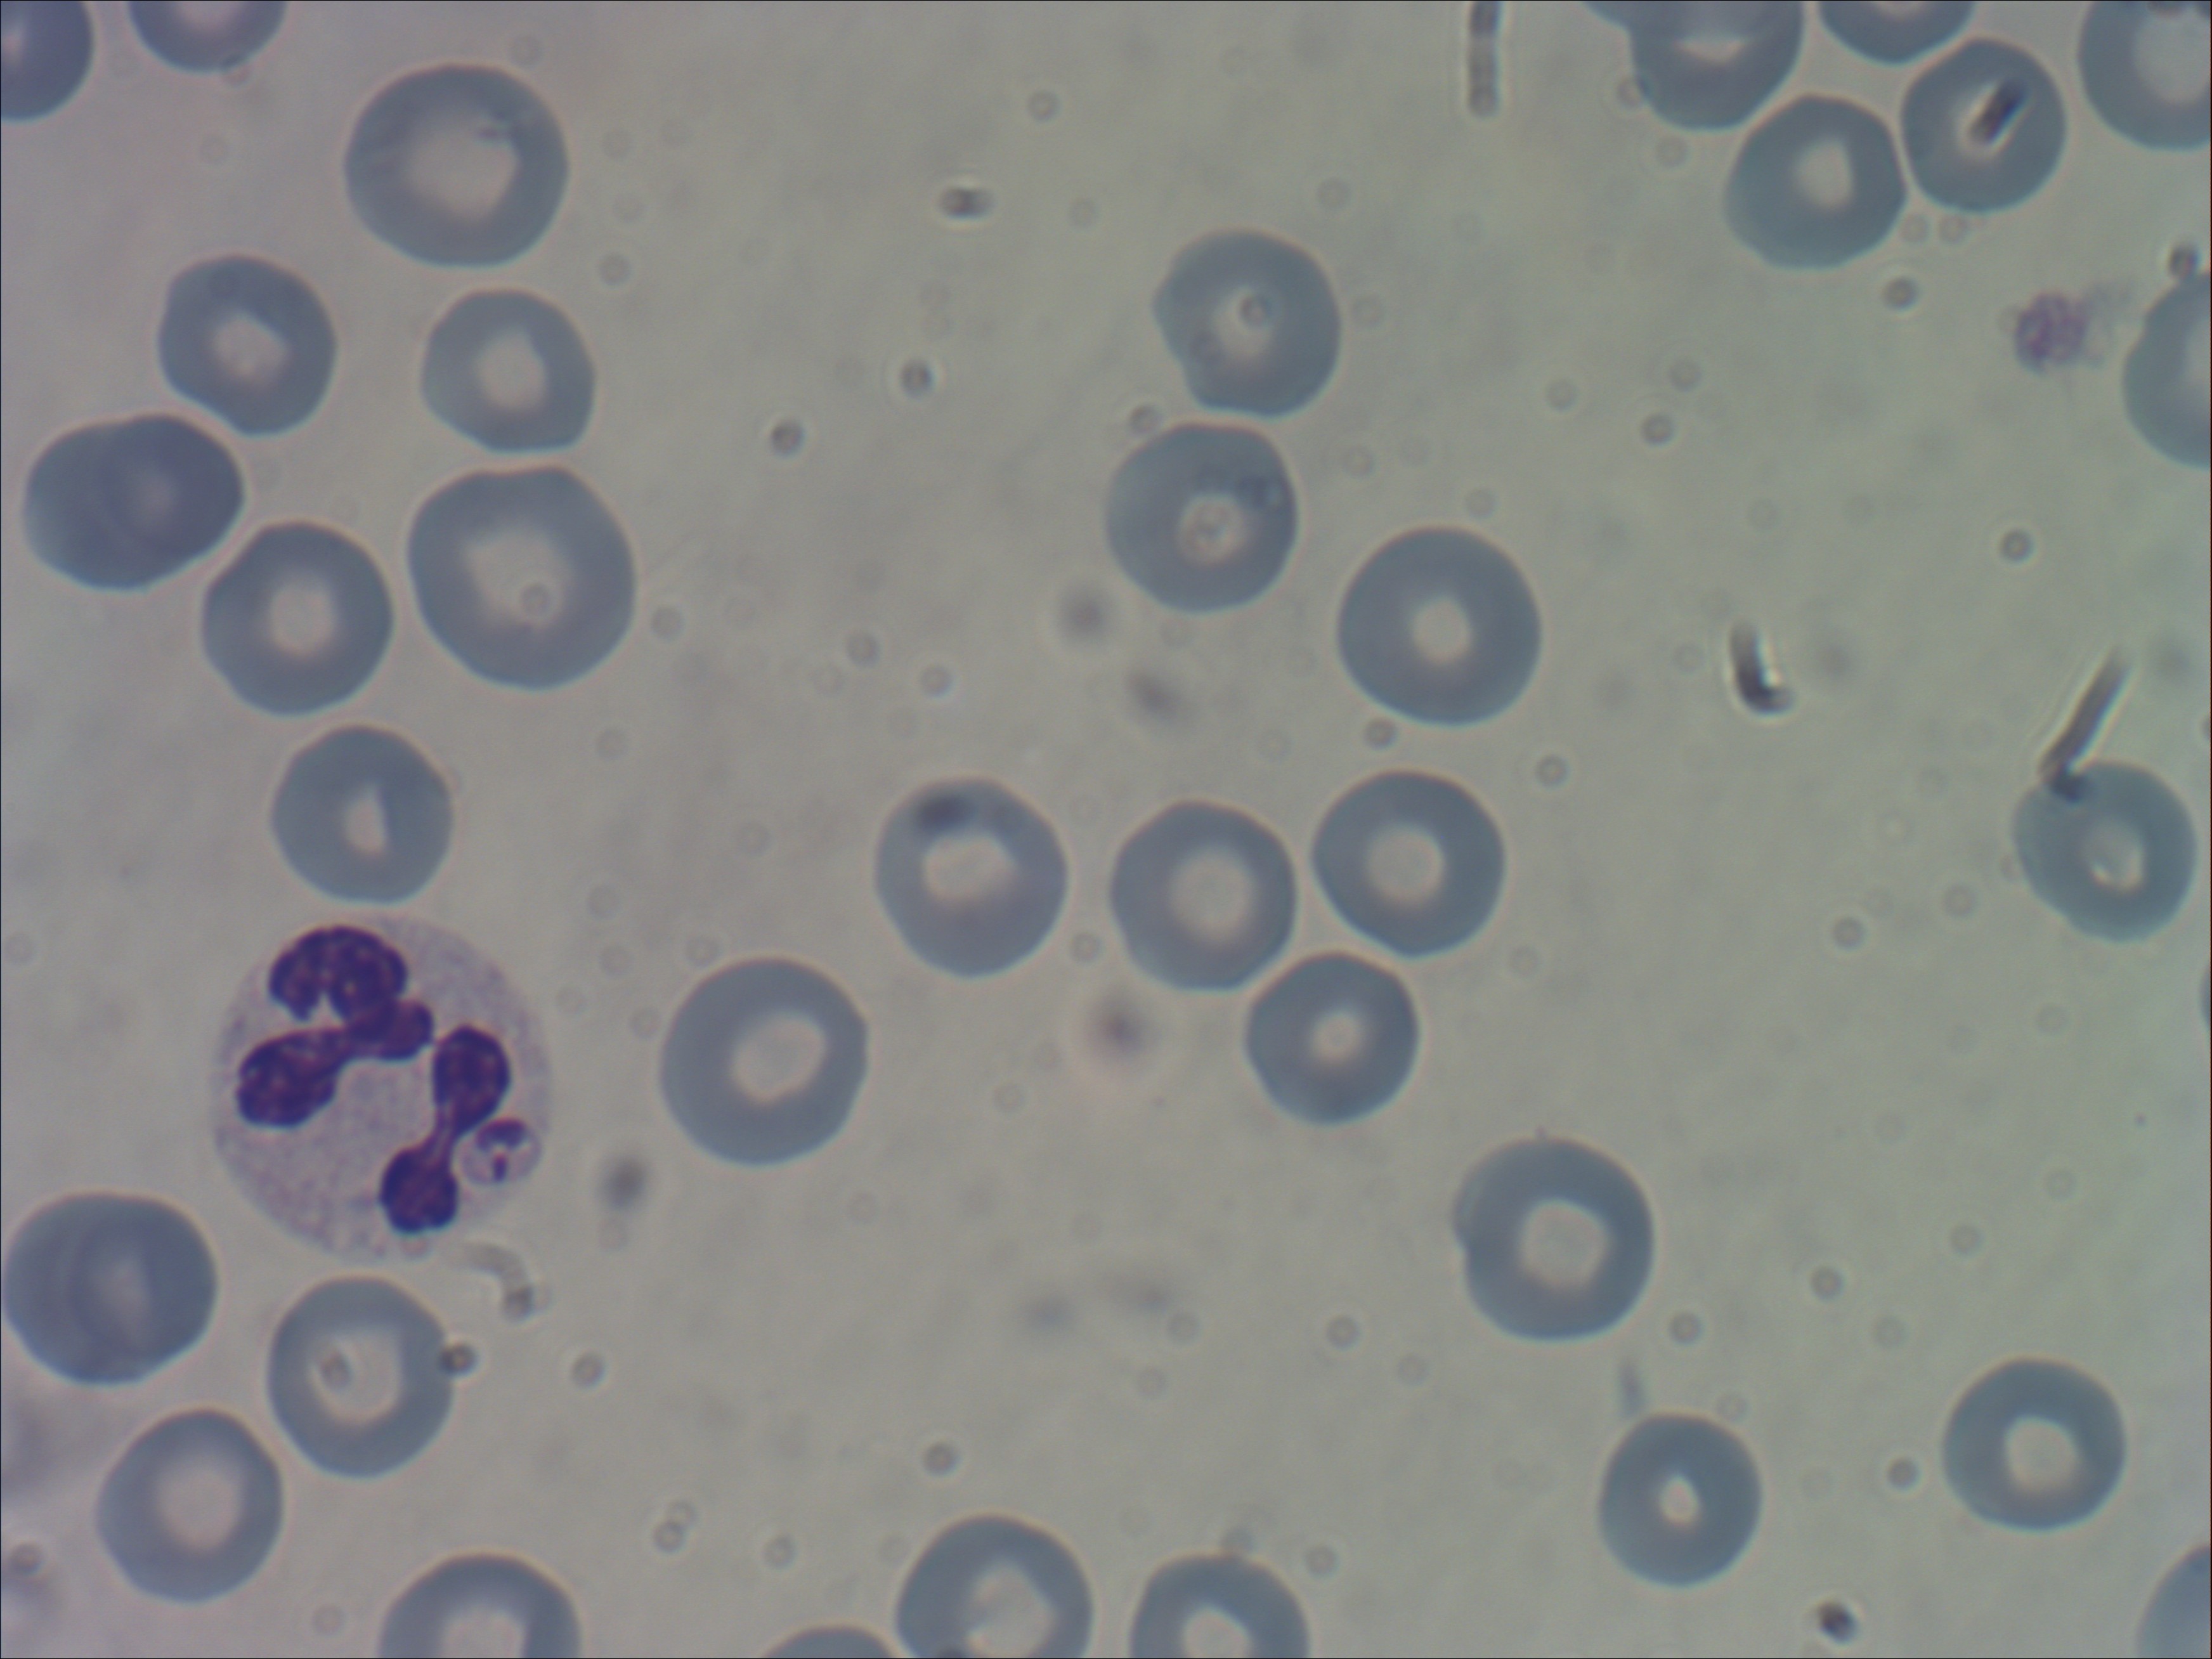

Infectieziekten Bulletin, juni 2024
Auteurs
Ayla Hesp1*, Katja van Ewijk1*, Marja de Jong2*, Sabiena Feenstra1, Titia Kortbeek1, Christine Piek2,
* Deze auteurs hebben een gelijke bijdrage aan dit artikel geleverd.
1. Centrum Infectieziektebestrijding, Rijksinstituut voor Volksgezondheid en Milieu (RIVM)
2. Faculteit Diergeneeskunde, Universiteit Utrecht
Inleiding
In januari 2023 nam een (Gemeentelijke Gezondheidsdienst) contact op met de (Landelijke coördinatie infectieziektebestrijding) over een prikaccident tijdens bloedafname bij een hond die verdacht werd van leishmaniasis. Het betrof een gezonde, 26-jarige vrouw, die werkte als dierenartsassistent. Het prikaccident vond plaats tijdens het werk. De assistente hield de hond vast, zodat de dierenarts bloed kon prikken. Door een onverwachte beweging van de hond kwam de naald (venapunctienaald) tijdens het prikken in de duim van de assistente terecht, waarbij er een oppervlakkig wondje ontstond dat een beetje bloedde. De assistente (casus) gaf aan dat er nauwelijks bloed was bij haarzelf door het prikaccident. Mogelijk was er ook nog geen bloed van de hond in de naald aangezogen.
De hond in deze casus was een Spaanse windhond van zeven jaar oud. De eigenaren van deze hond hadden meerdere Spaanse windhonden uit Spanje geadopteerd (onbekend wanneer), waaronder deze hond. De hond was acuut en ernstig ziek, met verschijnselen van nierfalen en malaise. Ook had de hond huidlaesies op de oorpunten. Bij honden zijn deze kenmerkend voor Leishmania. Om de diagnose leishmaniasis te stellen bij de hond, zette de dierenarts een (polymerase chain reaction) op (Ethyleendiaminetetra-azijnzuur)-bloed en serologisch onderzoek in. De PCR-uitslag was negatief en de serologie-uitslag werd iets later bekend: positief.
De vragen van de GGD aan LCI waren:
- Wat is het risico op zoönotische transmissie van Leishmania via een venapunctienaald?
- Welke maatregelen moeten genomen worden bij de dierenartsassistente?
- Hoe vaak komt leishmaniasis voor bij honden in Nederland?
Leishmaniasis bij de mens
Leishmania is een eencellige bloedparasiet (flagellaat), waarvan meer dan twintig verschillende soorten infectieus zijn voor mensen. Leishmania-parasieten bevinden zich intracellulair als amastigoten (stadium) in monocyten en macrofagen. Een infectie kan leiden tot verschillende ziektebeelden: cutane, mucocutane of viscerale leishmaniasis. De cutane vorm geeft een niet-genezende ulcus. De mucocutane vorm kan volgen op de cutane vorm, als de slijmvliezen van neus, mond en keel betrokken raken bij een ulcus1. Viscerale leishmaniasis wordt voornamelijk veroorzaakt door L. infantum, voorkomend in het Middellandse Zeegebied en Brazilië en door L. donovani, voorkomend in Zuidoost-Azië en Oost-Afrika1. Het aantal gevallen van viscerale leishmaniasis wereldwijd werd in 2015 geschat op 82.000 tot 164.000 casus per jaar (rekening houdende met onderrapportage)1. In Nederland wordt leishmaniasis alleen waargenomen bij mensen die de infectie hebben opgelopen in het buitenland.
Viscerale leishmaniasis is een ernstig ziektebeeld en wordt gekenmerkt door koorts, gewichtsverlies, spleno- en hepatomegalie en pancytopenie. De organen en het beenmerg raken aangetast door parasieten. Bij mensen met de klinische viscerale vorm is de ziekte zonder behandeling meestal fataal. Het ziektebeeld kan acuut ontstaan, maar ook geleidelijk. Veel geïnfecteerden met viscerale leishmaniasis raken latent geïnfecteerd, zonder verschijnselen, maar blijven at risk om symptomatisch te worden1.
De belangrijkste transmissieroute voor alle vormen van leishmaniasis is via zandvliegjes (Phlebotomus). Voor L. infantum is de hond het belangrijkste reservoir en daarmee de besmettingsbron voor zandvliegjes. De parasiet komt in het zandvliegje tot ontwikkeling van amastigoot tot promastigoot. Een besmet zandvliegje kan vervolgens de mens infecteren met promastigoten, wanneer het vliegje een bloedmaaltijd van de mens neemt. De incubatietijd is lang, enkele weken tot maanden. Mensen kunnen elkaar infecteren door het delen van injectienaalden waarin nog bloed aanwezig is (bijvoorbeeld intraveneuze druggebruikers).
Leishmania bij honden
De meest voorkomende variant van Leishmania bij honden is L. infantum, in Europa vooral in het Middellandse Zeegebied. Het ziektebeeld bij de hond wisselt sterk. Het kan beperkt zijn tot huidklachten, waarbij deze vaak gelokaliseerd zijn aan de extremiteiten. Het vastlopen van immuuncomplexen veroorzaakt vasculitis, met als gevolg crusteuze dermatitis. Dit is vooral aan de oorpunten duidelijk zichtbaar (Figuur 1). Ook ernstige systemische ziekte komt voor bij de hond, vergelijkbaar met viscerale leishmaniasis bij de mens. De incubatietijd bij de hond is lang, het kan maanden tot jaren duren na import of buitenlandbezoek voordat klinische verschijnselen optreden. Honden blijven vaak levenslang geïnfecteerd, net als mensen die de viscerale vorm van leishmaniasis hebben.
Figuur 1. Crusteuze dermatitis aan de oorpunten bij een hond met een Leishmania-infectie. N.B. De hond op de foto is niet de hond uit de casus.
De diagnose van leishmaniasis wordt gesteld aan de hand van een de combinatie van een passende anamnese (herkomst of bezoek aan een endemisch gebied), klinische verschijnselen, afwijkingen in het bloedbeeld (beta2- en/of hypergammaglobulinemie) en diagnostische testen die specifiek Leishmania aantonen. Bij een karakteristiek klinisch beeld voor Leishmania-infectie (bij honden met name de huidlaesies) volstaat een positieve titer. Onderbouwing van de diagnose leishmaniasis kan ook door in lymfoïde weefsels of het beenmerg Leishmania-amastigoten aan te tonen met cytologie (Figuur 2), of (deoxyribonucleic acid) aan te tonen met PCR. Bij honden met een Leishmania-infectie is er zelden sprake van een parasitemie (vrije parasieten in bloed).
Figuur 2. Bloeduitstrijkje met Leishmania-amastigoot in een neutrofiele granulocyt. Dit is zeldzaam, meestal wordt de parasiet gevonden in monocyten en macrofagen.|
N.B. Het bloedmonster op de foto is niet afkomstig van de hond uit de casus.
Honden in Nederland kunnen besmet zijn met Leishmania via drie verschillende routes. De eerste en belangrijkste is import van de hond uit een endemisch gebied. Er is sprake van een toegenomen verplaatsing van honden naar Nederland, vooral door import. Circa 11% van de honden die geïmporteerd worden uit endemische gebieden is seropositief voor Leishmania (ongepubliceerde data De Jong et al.). De tweede route is reizen met de hond naar een endemisch gebied. Hierbij blijkt uit onderzoek dat het risico op oplopen van een Leishmania-infectie tijdens een reis van gemiddeld twee weken voor de hond klein is2. De derde route is via autochtone infecties, dat wil in dit geval zeggen: infectie zonder tussenkomst van de zandvlieg, van hond naar hond, deze infecties zijn zeldzaam3. Overdracht tussen honden via sperma of transplacentale overdracht is mogelijk, maar komt in de praktijk maar heel weinig voor.
Voorkomen van de vector
In Europa zijn de zandvliegsoorten die Leishmania kunnen overdragen endemisch in het Middellandse Zeegebied, met name in Portugal, Spanje, Frankrijk en Italië. De afgelopen jaren wordt gezien dat het leefgebied van deze zandvliegjes zich geleidelijk uitbreidt en verplaatst naar het noorden van Europa4. Van de 50 soorten Phlebotomus, dragen slechts 11 soorten Leishmania over, waarvan maar een deel L. infantum betreft4. In 1999 werden zandvliegjes voor het eerst aangetoond in Duitsland. Sindsdien kom deze vector op verschillende plekken in Zuid-Duitsland voor5. Op plekken waar de zandvlieg zich gevestigd heeft, kunnen nieuwe infectiehaarden ontstaan als er op die plek ook honden zijn die de parasiet bij zich dragen. In stedelijke gebieden ontbreekt de typische zandvlieghabitat. Uit Spanje is bekend dat naast honden ook hazen als reservoir voor L. infantum kunnen dienen. Ook daarbij is altijd de vector nodig voor transmissie. In Nederland heeft de zandvlieg zich (nog) niet gevestigd en is leishmaniasis een importziekte.
Risico op zoönotische infectie
In onze casus is er mogelijk sprake geweest van bloed-bloedcontact. Omdat de transmissie van de parasiet normaal gesproken via de bloedmaaltijd van zandvlieg op mens plaatsvindt, is de vraag hoe groot het risico op transmissie is via bloed van een geïnfecteerde hond naar de mens.
In een studie bij Nederlandse hondenbezitters van honden met leishmaniasis werd geen overdracht gevonden van hond naar mens. Eigenaren van serologisch positieve honden waren zelf seronegatief2. Bij deze eigenaren was er geen bloedcontact met de hond bekend.
Uit de literatuur blijkt dat mens-op-mens transmissie van Leishmania via bloedcontact in specifieke gevallen mogelijk is. Van casuïstiek uit het verleden is bekend dat bij gevangenen die intraveneuze naalden deelden tijdens drugsgebruik, overdracht van Leishmania plaatsvond6. Maar bij honden bevindt de parasiet zich vooral in macrofagen in (lymfoïde) weefsels en zelden in het circulerend bloed in de bloedbaan. Amastigoten zitten wel in de hondenhuid op plekken waar de huid zichtbaar is aangedaan. Meestal is dat niet het halsgebied waar honden geprikt worden voor bloedafname. De kans op overdracht via de venapunctienaald in deze casus, waarbij er weinig of zelfs helemaal geen bloed in de naald zat en het wondje bij de casus minimaal was, werd door de parasitoloog en LCI-arts ingeschat als zeer klein.
Ingezette maatregelen bij een mogelijke blootstelling
Toediening van post-expositie profylaxe is in het geval van leishmaniasis niet mogelijk. De middelen die gebruikt worden voor behandeling van leishmaniasis hebben veel bijwerkingen en bij een aantal middelen is resistentie-ontwikkeling een probleem. Deze middelen zijn niet geschikt als profylaxe. Omdat viscerale leishmaniasis een ernstige ziekte is, adviseerde LCI het zekere voor het onzekere te nemen en de dierenartsassistente op te volgen door middel van serologie. Omdat de incubatietijd lang kan zijn (enkele weken tot maanden), was het advies om een nul-serum af te nemen en de serologie drie maanden later te herhalen. In het geval van seroconversie kan er dan worden overgegaan op behandeling. In Europa wordt als eerste keus vaak behandeld met liposomaal amfotericine B. Dat is minder toxisch vergeleken met andere middelen.
Verloop van de casus
De GGD heeft de dierenartsassistente voor het inzetten en opvolgen van de serologie overgedragen aan de huisarts. De serologie-nulmeting is afgenomen. Deze was negatief. Contact tussen dierenartsassistente en haar huisarts over de serologie-afname verliep moeizaam. De huisarts gaf aan onvoldoende kennis te hebben over het onderwerp. Er is daarbij helaas geen contact meer geweest met de GGD. Een jaar later heeft LCI contact gezocht met de GGD en de betreffende dierenartsenpraktijk om na te vragen hoe het verder is gegaan. De dierenartsassistente maakte het bij deze opvolging goed en verkeerde in goede gezondheid. Ze voelde daardoor niet de noodzaak om toch de serologie te herhalen en opnieuw contact op te nemen met de GGD of huisarts.
Bij bespreking van deze casus door betrokken professionals en deskundigen op gebied van humane en veterinaire leishmaniasis, werd nog aangegeven dat opvolging na drie maanden mogelijk te snel is. Het kan langer dan drie maanden duren voor er seroconversie optreedt. Serologie is bij de mens wel een gevoelige methode om viscerale leishmaniasis aan te tonen.
Ook de hond maakt het een jaar later goed. Hij heeft (na een behandeling met allopurinol) geen klinische afwijkingen meer: niet bij het lichamelijk onderzoek en ook in het bloed zijn de waarden voor lever en nieren normaal. Wel heeft hij nog een hoge antilichaamtiter. Net als bij de mens blijven honden met leishmaniasis vaak levenslang geïnfecteerd. Daarom is halfjaarlijkse controle door de dierenarts geïndiceerd. Bij recidief moet hernieuwde behandeling plaatsvinden. Bij de hond zijn de aangetaste oorpunten inmiddels geopereerd. Overigens zijn bij veel behandelde honden de huidveranderingen aan de oren reversibel. Na de operatie van de hond geeft de dierenarts aan: ‘Het zijn niet de mooiste oren, maar hij heeft er nu in ieder geval geen ongemak meer van.’
Conclusie
Bij deze casus werd het risico op zoönotische transmissie van hond naar mens door een prikaccident ingeschat als zeer klein. Redenen hiervoor waren dat bij de hond de PCR op volbloed negatief was (geen vrije parasieten in het bloed) en de kans op overdracht van macrofagen via bloed werd ingeschat als verwaarloosbaar bij dit (minimale) prikaccident. De algemene conclusie is dat het risico op overdracht vanuit honden naar mensen zonder tussenkomst van de zandvlieg erg klein is. Wel kan bij mensen in Nederland vaker leishmaniasis gaan voorkomen, omdat vanwege klimatologische veranderingen het leefgebied van de vector voor Leishmania zich uitbreidt naar Noordwest Europa.
Leishmaniasis bij honden in Nederland wordt met enige regelmaat gediagnosticeerd, en waarschijnlijk neemt het aantal besmettingen bij honden toe. Omdat leishmaniasis bij de hond niet aangifteplichtig is, ontbreken de data van het exacte aantal cases. Het aantal importhonden uit endemische gebieden (met name Zuid-Europa) neemt toe. In onderzoek bij uit deze gebieden geïmporteerde honden in Nederland werd ca. 11% seropositief bevonden voor Leishmania. Dit onderschrijft de verdenking dat er nu meer besmette honden in Nederland zijn dan voorheen.
De inschatting is nu dat de rol van honden in Noordwest-Europa in het voorkomen van Leishmania bij mensen minimaal is. Geïnfecteerde huishonden hebben (mits behandeld) nihil aanwezige Leishmania in het bloed en bij huiselijk contact met honden vindt waarschijnlijk geen overdracht plaats naar de mens.
Met betrekking tot de afhandeling van de casus, gaf de dierenartsenpraktijk aan zeer tevreden te zijn over de adviserende rol van LCI en GGD. Het contact tussen de GGD en de huisarts is mogelijk onderwerp voor evaluatie. Blijkbaar was het voor de huisarts onvoldoende duidelijk wat er moest gebeuren. Mogelijk had de GGD hierbij nog een ondersteunende rol kunnen spelen. Samenvattend was deze casus aanleiding tot een nuttige discussie tussen de betrokken (veterinaire) public-health-professionals over het zoönotische risico bij dit prikaccident.
Het tot stand brengen van dit artikel gebeurde in samenwerking tussen de Landelijke Coördinatie Infectieziektebestrijding (LCI) van het (Centrum Infectieziektebestrijding (onderdeel van het RIVM)), RIVM en veterinair specialisten interne geneeskunde van de Faculteit Diergeneeskunde, Universiteit Utrecht.
- Aronson NE CN, Magill AJ. Visceral, Cutaneous, and Mucosal Leishmaniasis. In: Bennett JE DR, Blaser MJ, editor. Mandell, Douglas, and Bennett's principles and practice of infectious diseases. Philadelphia: Elsevier Saunders; 2015. p. 3321.
- Teske E, van Knapen F, Beijer (Europese Gemeenschap), Slappendel RJ. Risk of infection with Leishmania (species). in the canine population in the Netherlands. Acta Vet Scand. 2002;43(4):195-201.
- Slappendel RJ. Canine leishmaniasis. A review based on 95 cases in The Netherlands. Vet Q. 1988;10(1):1-16.
- (European Centre for Disease Prevention and Control). Phlebotomine sand flies - Factsheet for experts 2024. Beschikbaar via: https://www.ecdc.europa.eu/en/disease-vectors/facts/phlebotomine-sand-flies. Geraadpleegd april 2024.
- Oerther S, Jöst H, Heitmann A, Lühken R, Krüger A, Steinhausen I, et al. Phlebotomine sand flies in Southwest Germany: an update with records in new locations. Parasites & Vectors. 2020;13(1):173.
- Cruz I, Morales MA, Noguer I, Rodríguez A, Alvar J. Leishmania in discarded syringes from intravenous drug users. Lancet. 2002;359(9312):1124-5.
Infectieziekten Bulletin - juni 2024
- Een prikaccident tijdens bloedafname bij een hond met Leishmania: zoönotisch risico of niet?
- Infectiepreventie in dagvoorzieningen voor mensen met een verstandelijke beperking; Wat is de kennis, behoefte en praktijkervaring?
- Geluid van de samenleving; Het betrekken van burgers bij het maken van beleid over uitbraakmanagement
- Het effect van inhaalvaccinaties op de vaccinatiegraad
- Promotieonderzoek: herhaalvaccinatie zorgt voor betere afweer tegen kinkhoest